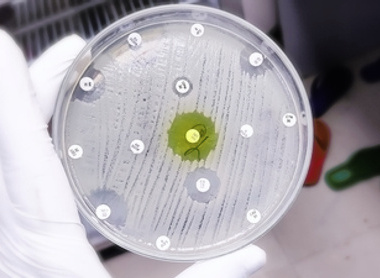
Antimicrobial susceptibility testing picture

Public affairs & on the agenda
The College works to support and promote the interests of pathologists, patients and students through developing links with UK parliaments and assemblies. The College provides information and advice on pathology to politicians, civil servants, opinion formers and decision makers.
On the agenda
Our On the agenda pages outline the College's position on topical subject areas in pathology. Find out more via the pages below:
Read our College member responses to consultations on key issues
Our College responses reflect comments made by Fellows and members in response to requests for input to consultations.